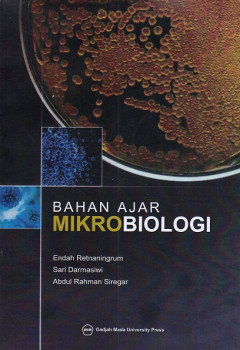
cover

Ditapis dengan
Ditemukan 2 dari pencarian Anda melalui kata kunci: author=Endah Setyaningrum

Penyakit tular vektor berbasis lingkungan
Penyakit tular vektor berbasis lingkungan berisi tentang, Pendahuluan, Penyakit tular vektor berbasis lingkungan, Binatang pembawa penyakit tular vektor, Faktor lingkungan penyakit tular vektor.
- Edisi
- Cet.1
- ISBN/ISSN
- 978-602-5990-69-4
- Deskripsi Fisik
- viii, 78 hlm.: ilus.; 24 cm.
- Judul Seri
- -
- No. Panggil
- 614.43 END p
Bahan ajar Mikrobiologi
Bahan ajar Mikrobiologi berisi tentang, Pengantar dan sejarah perkembangan mikrobiologi, Metode mikrobiologi, Keanekaragaman mikrobia, Struktur dan perkembangan mikrobia seluler dan aseluler, Nutrisi dan Metabolisme mikrobia, Prtumbuhan populasi mikrobia, Pengendalian pertumbuhan mikrobia, Genetika mikrobia, Aplikasi mikrobiologi.
- Edisi
- Cet.1
- ISBN/ISSN
- 978-602-386-175-0
- Deskripsi Fisik
- xvi, 152 hlm.: ilus.; 20,5 cm.
- Judul Seri
- -
- No. Panggil
- 616.01 END b
 Karya Umum
Karya Umum  Filsafat
Filsafat  Agama
Agama  Ilmu-ilmu Sosial
Ilmu-ilmu Sosial  Bahasa
Bahasa  Ilmu-ilmu Murni
Ilmu-ilmu Murni  Ilmu-ilmu Terapan
Ilmu-ilmu Terapan  Kesenian, Hiburan, dan Olahraga
Kesenian, Hiburan, dan Olahraga  Kesusastraan
Kesusastraan  Geografi dan Sejarah
Geografi dan Sejarah